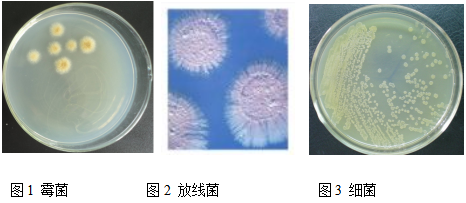

一、 实验原理
土壤中微生物的种类较多,有细菌、真菌、放线菌、藻类和原生动物等。微生物的数量也非常庞大,1克土壤中一般会有几亿到几百亿个。其种类和数量随成土环境及其土层深度的不同而变化。
土壤微生物作为土壤 活跃的成分,与土壤资源可持续利用密切相关。从土壤中分离、提纯并鉴定相应的微生物,对于提高土壤质量,保障我国粮食安全与生态安全都具有潜在的价值。现在对于土壤生态系统中微生物群落多样性及结构的研究大多采用分离培养的方式,从固体培养基上分离微生物,然后通过对生化特性或者特定表现型的分析,初步了解土壤微生物的生活特征和生态功能的信息。
二、实验目的
1.通过稀释平板法分离、纯化微生物,并对微生物进行鉴定。
2.培养不同微生物并进行计数。
三、材料及用具
试剂:牛肉膏,蛋白胨,NaCl,琼脂,NaOH,HCl,可溶性淀粉,硝酸钾,磷酸氢二钾,硫酸镁,硫酸亚铁,硝酸钠,氯化钾,蔗糖,乳酸,苯酚,乙醇,香柏油,二甲苯,乳酸石碳酸棉蓝染色液,0.1%美蓝染色液。
用具:锥形瓶,玻璃棒,容量瓶,烧杯,棉塞,培养皿,接种针,玻璃试管,涂布器,小铁铲,报纸,玻璃珠,载玻片,盖玻片,镊子,擦镜纸,酒精灯。
四、实验步骤
1.培养基的配制
(一)牛肉膏蛋白胨固体培养基

秤取:准确秤取上述各种成分,秤取时动作要迅速,称后及时盖上瓶盖。
溶化:先将牛肉膏量筒称量纸一同放入烧杯,加少量水,加热至牛肉膏溶化并与称量纸分离后,用玻璃棒取出称量纸。加入蛋白胨和氯化钠,用玻璃棒搅拌使之溶解,再加入琼脂,搅拌,待溶解后,加自来水定容至1000 mL。
调节pH:使用pH计,以1mol/L的NaOH或1mol/L的HCl调节pH至7.0~7.2.
分装:分装过程中注意不要使培养基沾在管口或瓶上,以免沾污棉塞而引起污染。分装锥形瓶的量以不超过瓶容量的一半为宜。
(二)高氏1号培养基

配制时,先用少量冷水将淀粉调成糊状,倒入煮沸的水中,在火上加热,边搅拌边加入其它成分,溶化后,补足水分至1000 mL。121℃灭菌20 min。
(三)查氏培养基

制法:加热溶解,分类后121℃灭菌20 min。
2. 器具和培养基的灭菌
将配制好的培养基放入锥形瓶中(瓶口加棉塞,包上报纸),连同培养皿、接种针、分装在玻璃试管中的纯水、涂布器、锥形瓶、80%乳胶、小铁铲、信封等用几层报纸包好,一起放到高压锅内,在压力为100kPa、温度为121℃,灭菌20min。
3. 倒平板
在酒精灯附近,待培养基冷却到55℃左右倒平板。查氏培养基倒平板前需另外加入1 mL80%乳酸/1000 mL,高氏1号培养基在倒平板前需另外加入4 mL10%酚液/1000 mL。
4. 土壤取样
于肥沃、湿润的土壤,铲去表层土5cm左右,再取样,将样品装入事先准备好的信封中。
5. 土壤样品的稀释
制备土壤悬浮液:秤取土样10 g,迅速倒入带玻璃珠的90 mL无菌水瓶中(玻璃珠用量以充满瓶底 ),震荡5~10min,使土样充分打散,即配成10-1稀释度的土壤悬浮液。用无菌移液管吸10-1的土样悬浮液1 mL,放入9 mL无菌水中即得到10-2稀释液,如此重复,可依制成10-2~10-6的稀释土壤悬浮液。
6. 微生物分离与纯化—涂布平板法
吸取上述稀释度为10-2、10-3、10-6的土壤悬浮液1 mL,通过涂布平板法分别接种到查氏培养基、高氏1号培养基、牛肉膏蛋白胨培养基中,用于霉菌、放线菌、细菌的分离与纯化。
7. 恒温箱中微生物的培养
将接种和一个未接种的空白对照培养皿倒置放入恒温箱中,于28~30℃中恒温培养:细菌培养1~2天,放线菌培养5~7天,霉菌培养3~5天。
8. 微生物菌落形态的观察和计数
微生物菌落形态可以直接通过肉眼观察,记录并描述菌落的大小、形态、边缘、光泽、质地、颜色和透明程度等形态特征。在进行恒温培养时,每隔24小时统计一次菌落数目。在同一稀释度下,至少对3个平板进行重复计数,然后求出平均值,并根据平板所对应的稀释度计算出样品中微生物的数目,具体计算公式见下:
每克样品中的菌数=(C/V)×M
C:代表某一稀释度下平板上生长的平均菌落数。
V:代表涂布平板时所用的稀释液的体积。
M:稀释的倍数。
四、实验结果